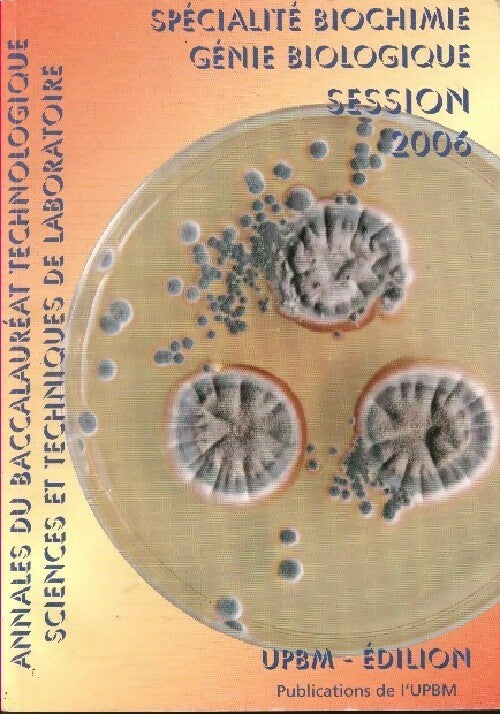

1
/
de
1
Annales 2006 baccalauréat technologique sciences techniques de laboratoire
Annales 2006 baccalauréat technologique sciences techniques de laboratoire
-
Grand Format
-
Français
Garantie 30 jours
Satisfait ou remboursé sous 30 jours. Retour simple et rapide.Voir la politique de retours
Un achat engagé
Soutenez une coopérative à but non lucratif
Produit collecté, stocké et traité en France
Articles d'occasion contrôlés